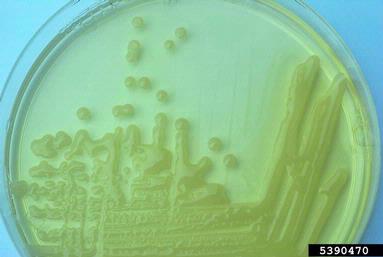

4. Toxinas
![]() |
| Image 44. Elaboración propia |
- Cuando estaba en el hospital ha sucedido algo bastante desagradable.
- En la habitación de al lado, una persona de 38 años ha sido intervenida para realizarle un trasplante de hígado, como consecuencia de la ingesta de setas venenosas.
- Hace sólo unos pocos días antes, los periódicos publicaron una noticia parecida, pero en este caso con un fatal desenlace: "Muere en el hospital el hombre que ingirió setas venenosas".
- Mi padre es muy aficionado a recoger setas en el campo, para consumirlas en casa. Cada año me da más miedo que haga estas cosas...
- Pero, ¿qué es exactamente lo que producen algunas especies de setas que nos puede causar hasta la muerte?
![]() |
| Imagen 45. Autor: Albert Bridge. Licencia Creative Commons |
Lee este artículo de la Wikipedia sobre las toxinas y sus diferentes tipos.
¿A qué tipo de toxina crees que pertenece la ingerida por el señor que falleció?
![]() |
| Imagen 46. Autor: Donald Groth. Licencia Creative Commons |
Ya adelantamos en el apartado anterior que la patogenecidad de algunas bacterias reside en su capacidad para producir toxinas. Pero, ¿qué tipos de toxinas existen en cuanto a su localización en la bacteria?
Puedes descubrirlo en esta página de la web Ciencia Real, y después trata de contestar a las siguientes cuestiones.
|
Enterotoxinas y neurotoxinas. | |
|
Exotoxinas y endotoxinas. | |
|
Citotoxinas y endotoxinas. |
¿Qué diferencia existe, entonces, entre las exotoxinas y las endotoxinas?
|
Básicamente, dónde actúan; las primeras fuera del organismo invadido y las segundas en su interior. | |
|
Su comportamiento físico. | |
|
Las primeras son liberadas a los fluidos corporales del hospedador y las segundas no. |
Prueba a realizar este crucigrama, para conocer los distintos tipos de toxinas según el tejido, órgano o sistema que atacan.
Puedes consultar estos enlaces para resolverlo, aunque algunas son fáciles de deducir:
- Definición de neurotoxina.
- Sobre la conotoxina.
- Definición de necrotoxina.
- Página de Wikipedia sobre toxinas.
| 2 | ||||||||||||||||||
|
|
3 | |||||||||||||||||
| 1 | C | A | R | O |
||||||||||||||
| U | ||||||||||||||||||
| 1 | ||||||||||||||||||
| 3 | I | T | ||||||||||||||||
| R | ||||||||||||||||||
| 2 | H | O | N | |||||||||||||||
|
Horizontales:
|
Verticales:
|
La acción de las toxinas puede tener como objetivos:
- Alterar el metabolismo de las células.
- Preservar la supervivencia del agente patógeno en el organismo afectado.
- Romper células de tejidos.